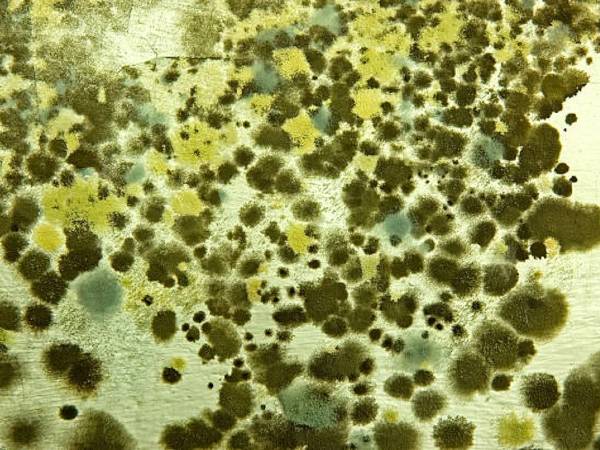
அஸ்பெர்கில்லோசிஸ் எங்கிருந்து வருகிறது?

Latest Updates
-
July 2026: ஜூலை மாதத்தின் முக்கியமான நாட்கள் மற்றும் விரத தினங்கள் என்னென்ன தெரியுமா? -
2 பிரட்டும், அரை கப் கடலை மாவும் இருந்தா டக்குனு இந்த டிபனை பண்ணுங்க - டேஸ்ட்டா, ஆரோக்கியமா இருக்கும் -
சனிபகவான் வக்ர பெயர்ச்சியை தொடங்கப் போவதால் பணத்தையும், புகழையும் குவிக்கப்போகும் 3 ராசிகள் -
ட்ராபிக் சிக்னலில் ஏன் உலகம் முழுக்க சிவப்பு, மஞ்சள், பச்சை நிறம் மட்டுமே பயன்படுத்தப்படுகிறது தெரியுமா? -
முட்டைக்கோஸ் இருந்தா இந்த மாதிரி ஆந்திரா ஸ்டைலில் பிரியாணி செஞ்சு பாருங்க - கமகமனு சூப்பரா இருக்கும் -
July 2026 Horoscope: இந்த 4 ராசிக்காரங்க ஜூலை மாதத்தில் கொடிகட்டி பறக்கப்போறாங்களாம் - உங்க ராசி இதுல இருக்கா? -
1 கப் சேமியா இருந்தா.. காலையில் ஒருடைம் இந்த டிபனை செய்யுங்க.. ருசியானதும், சத்தானதும் கூட.. -
இன்றைய ராசிபலன் 24 ஜூன் 2026: இன்று இந்த 4 ராசிக்காரங்களுக்கு ரொம்ப துரதிர்ஷ்டமான நாளாக இருக்குமாம் -
ஜூலை 02-ல் நடக்கும் சனி நட்சத்திர பெயர்ச்சி: இந்த 4 ராசிக்கு பண வரவு அதிகரிக்கும்.. -
மழைக்காலத்தில் சரும நிறத்தை அதிகரிக்கணுமா? இந்த ஃபேஸ் பேக்கை போடுங்க...
கொரோனாவில் இருந்து மீண்டவர்களைத் தாக்கும் பச்சை பூஞ்சை தொற்று - ஆரம்ப அறிகுறிகள் என்ன? தடுப்பது எப்படி?
மத்திய பிரதேசத்தின் இந்தூரில் கொரோனாவில் இருந்து மீண்ட 34 வயதான ஒருவருக்கு பச்சை பூஞ்சை தொற்று இருப்பது கண்டறியப்பட்டுள்ளது. மேலும் இவர் சிகிச்சைக்காக மும்பையில் உள்ள மற்றொரு மருத்துவமனைக்கு அவசரமாக மாற்றப்பட்டுள்ளார்.
கொரோனாவில் இருந்து மீண்டவர்கள் மிகவும் எச்சரிக்கையாகவும் இருக்க வேண்டும். கொரோனாவில் இருந்து மீண்ட பிறகு உடலுக்கு போதுமான கவனம் செலுத்தாமல் இருந்தால், அது பல சிக்கல்களுக்கு வழிவகுக்கும். ஏற்கனவே கொரோனாவில் இருந்து மீண்டவர்களை கொடிய கருப்பு பூஞ்சை தொற்று பாடாய் படுத்தி தொந்தரவு செய்கின்றன.

கருப்பு பூஞ்சைக்கு பிறகு, அதை விட கொடிய வெள்ளை பூஞ்சை தொற்று வழக்கு பதிவானது. அதோடு இல்லாமல் வெள்ளை பூஞ்சை விட அபாயகரமான மஞ்சள் பூஞ்சை வழக்கு பதிவானது. தற்போது மத்திய பிரதேசத்தின் இந்தூரில் கொரோனாவில் இருந்து மீண்ட 34 வயதான ஒருவருக்கு பச்சை பூஞ்சை தொற்று இருப்பது கண்டறியப்பட்டுள்ளது. மேலும் இவர் சிகிச்சைக்காக மும்பையில் உள்ள மற்றொரு மருத்துவமனைக்கு அவசரமாக மாற்றப்பட்டுள்ளார்.

இந்தியாவின் முதல் பச்சை பூஞ்சை வழக்கு
மத்திய பிரதேசத்தின் இந்தூரில் 34 வயதான கொரோனாவில் இருந்து குணமான ஒருவருக்கு பச்சை பூஞ்சை தொற்று இருப்பது கண்டறியப்பட்டுள்ளது. இதுக்குறித்து மார்பு நோய்களின் HOD டாக்டர் ரவி தோசி கூறியதாவது, "கோவிட்-19 இலிருந்து மீண்ட அந்நபருக்கு கொடிய கருப்பு பூஞ்சை தொற்று இருப்பதாக சந்தேகிக்கப்பட்டதால் ஒரு பரிசோதனை மேற்கொள்ளப்பட்டது. அந்த சோதனையில் கருப்பு பூஞ்சை தொற்றுக்கு பதிலாக பச்சை பூஞ்சை தொற்று இருப்பது கண்டறியப்பட்டது. இந்த பச்சை பூஞ்சையால் அவரது நுரையீரல், சைனஸ்கள் மற்றும் இரத்தத்தில் தொற்றால் பாதிக்கப்பட்டுள்ளது தெரிய வந்தது" என்றார்.
அதோடு கோவிட்-19 இலிருந்து மீண்டு வருபவர்களுக்கு பச்சை பூஞ்சை தொற்று மற்ற நோயாளிகளிடமிருந்து வேறுபட்டதா என்பதை அறிய கூடுதல் ஆராய்ச்சி தேவைப்படுகிறது என்றும் கூறினார்.

மூக்கில் இரத்தக்கசிவு
பச்சை பூஞ்சை தொற்று ஏற்பட்ட அந்நபர் இரண்டு மாதங்களுக்கு முன் நுரையீரலில் கிட்டத்தட்ட 100 சதவீத கொரோனா வைரஸ் தொற்றுடன் உள்ளூர் மருத்துவமனையில் அனுமதிக்கப்பட்டு ஐ.சி.யுவில் சுமார் ஒரு மாதம் சிகிச்சை பெற்றார். கொரோனாவில் இருந்து முழுமையாக குணமடைந்த பின்னர், அவருக்கு மூக்கில் இருந்து இரத்தம் வடிந்தது மற்றும் அதிக காய்ச்சலும் வர ஆரம்பித்தது. மேலும் தீவிர எடை இழப்பு காரணமாக அவர் மிகவும் பலவீனமாகிவிட்டார் என்றும் மருத்துவர் கூறினார்.
இப்போது பச்சை பூச்சை என்றால் என்ன, அதன் அறிகுறிகள் என்ன, எப்படி பரவும், எதனால் பரவுகிறது, தொற்றுநோயா, சிகிச்சை முறைகள் என்ன என்பன போன்ற கேள்விகளுக்கான விடையைப் பார்ப்போம்.

பச்சை பூஞ்சை அல்லது அஸ்பெர்கில்லோசிஸ் என்றால் என்ன?
அஸ்பெர்கில்லோசிஸ் என்பது அஸ்பெர்கில்லஸால் ஏற்படும் ஒரு தொற்று ஆகும். இது உட்புறத்திலும் வெளியிலும் வாழும் ஒரு பொதுவான பூஞ்சை. பெரும்பாலான மக்கள் ஒவ்வொரு நாளும் ஆஸ்பெர்கில்லஸ் பூஞ்சையால் நோய்வாய்ப்படாமல் சுவாசித்து வருகிறார்கள்.

பச்சை பூஞ்சை அல்லது அஸ்பெர்கிலஸின் வகைகள் என்ன?
பெரும்பாலான சந்தர்ப்பங்களில், அஸ்பெர்கில்லோசிஸ் அஸ்பெர்கில்லஸ் ஃபுமிகேடஸ் எனப்படும் ஒரு வகை பூஞ்சை காரணமாக ஏற்படுகிறது. அஸ்பெர்கில்லஸில் சுமார் 180 இனங்கள் உள்ளன. ஆனால் அவற்றில் 40-க்கும் குறைவானவை மனிதர்களில் தொற்றுநோய்களை ஏற்படுத்துகின்றன. மனிதர்களுக்கு ஏற்படும் அஸ்பெர்கில்லஸ் நோய்த்தொற்றுகளுக்கு அஸ்பெர்கிலஸ் ஃபுமிகேடஸ் மிகவும் பொதுவான காரணம். இருப்பினும், பல்வேறு வகையான அஸ்பெர்கில்லோசிஸ் வெவ்வேறு அறிகுறிகளைக் கொண்டுள்ளன.
அஸ்பெர்கில்லோசிஸ் எங்கிருந்து வருகிறது?
அஸ்பெர்கில்லஸ், சாதாரணமாக உட்புறத்திலும் வெளிப்புறத்திலும் வாழக்கூடிய மிகவும் பொதுவான பூஞ்சை வகை தான். பெரும்பாலான மக்கள் ஒவ்வொரு நாளும் இந்த பூஞ்சை வித்திகளை சுவாசிக்கிறார்கள்.

இது எவ்வாறு பரவுகிறது?
ஆரோக்கியமான நோயெதிர்ப்பு சக்தியைக் கொண்டவர்களுக்கு அஸ்பெர்கில்லஸ் தீங்கு விளைவிப்பதில்லை. இருப்பினும், பலவீனமான நோயெதிர்ப்பு மண்டலம் உள்ளவர்கள் அஸ்பெர்கில்லஸ் பூஞ்சையை சுவாசித்தால், அது நுரையீரல் அல்லது சைனஸில் தொற்றுநோயை ஏற்படுத்தி உடலின் மற்ற பகுதிகளுக்கும் பரவக்கூடும். அஸ்பெர்கில்லஸ் பூஞ்சை தொற்றிற்கு சிகிச்சையளிக்கப்படாவிட்டால், அது நிமோனியாவை ஏற்படுத்தும்.

அஸ்பெர்கில்லோசிஸுக்கு என்ன காரணம்?
* உர குவியல்கள்
* சேமிக்கப்பட்ட தானியங்கள்
* மரிஜுவானா இலைகள்
* அழுகிய தாவரங்கள்

பச்சை பூஞ்சை தொற்றின் அறிகுறிகள்
* மூச்சுத் திணறல்
* சுவாசிப்பதில் சிரமம்
* இருமல்
* காய்ச்சல் (அரிய சந்தர்ப்பங்களில்)

பிற அறிகுறிகள்
பல்வேறு வகையான அஸ்பெர்கில்லோசிஸின் பிற அறிகுறிகள் பின்வருமாறு:
* நெஞ்சு மற்றும் எலும்புகளில் வலி
* பார்ப்பதில் சிரமம்
* சிறுநீரில் இரத்தம்
* குறைவான சிறுநீர் கழிப்பது
* தலைவலி
* குளிர்
* மூச்சுத்திணறல்
* சரும புண்கள்
* இரத்தம் கலந்த சளி
இது தொற்றுநோயா?
அஸ்பெர்கில்லோசிஸ் தொற்றுநோய் அல்ல. மேலும் இது ஒருவரிடமிருந்து மற்றொருவருக்கு பரவ முடியாது.

அஸ்பெர்கில்லோசிஸ் சிகிச்சைகள்
மருந்து: பூஞ்சை எதிர்ப்பு மருந்துகள் அனைத்து வகையான நோய்களுக்கும் சிகிச்சை அளிக்கிறது. வோரிகோனசோல் போன்ற வாய்வழி அல்லது நரம்பு மருந்துகள் கொடிய வகை அஸ்பெர்கில்லோசிஸுக்கு சிகிச்சையளிக்கும்.
அறுவை சிகிச்சை: அஸ்பெர்கில்லோசிஸ் நோயால் தீவிரமாக பாதிக்கப்பட்டவர்களுக்கு சில நேரங்களில் அறுவை சிகிச்சை கூட தேவைப்படலாம்.

தடுப்பு முறைகள்
அஸ்பெர்கில்லஸ் பூஞ்சைகளை சுவாசிப்பதைத் தவிர்ப்பது கடினம். ஏனெனில் இது பொதுவான சூழலில் இருக்கக்கூடியது. நோயெதிர்ப்பு சக்தி பலவீனமாக இருப்பவர்களுக்கு கடுமையான ஆஸ்பெர்கிலஸ் தொற்று ஏற்படுவதற்கான வாய்ப்புகளை குறைக்க சில வழிகள் உள்ளன. அவை பின்வருமாறு:
* கட்டுமானம் அல்லது அகழ்வாராய்ச்சி தளங்கள் போன்ற தூசிகள் நிறைந்த பகுதிகளுக்கு செல்வதைத் தவிர்க்க முயற்சி செய்யுங்கள். இந்த பகுதிகளுக்கு செல்வதை தவிர்க்க முடியாவிட்டால், அங்கு செல்லும் போது N95 சுவாசக் கருவியை (ஒரு வகை முகமூடி) அணியுங்கள்.
* மண் அல்லது தூசிகள் போன்றவற்றுடன் நெருங்கிய தொடர்பு கொள்ளும் செயல்களைத் தவிர்த்திடுங்கள்.
* சரும தொற்று ஏற்படுவதற்கான அபாயத்தைக் குறைக்க, சருமத்தில் ஏற்பட்டுள்ள காயங்களை சோப்பு மற்றும் நீரால் நன்கு சுத்தம் செய்யுங்கள். குறிப்பாக மண் அல்லது தூசி அந்த காயங்களில் பட்டிருந்தால், தவறாமல் அப்பகுதியை சோப்பு பயன்படுத்தி சுத்தம் செய்யுங்கள்.



Click it and Unblock the Notifications